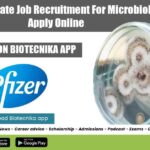
Pfizer Associate Job Recruitment
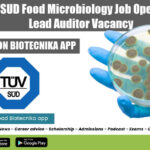
TUV SUD Food Microbiology

Home Search
biology - search results
If you're not happy with the results, please do another search
FREE WEBINAR On Career & Future In Computational Biology – Register Now
Computational Biology Career & Future - Career Guidance Webinar Biotecnika
Computational Biology - Words when we read, our mind drifts off to “oh this is...
TERI Technical Assistant Job For Biotech, Life Sciences, Microbiology
TERI Technical Assistant Job For Biotech, Life Sciences, Microbiology
TERI Technical Assistant Job For Biotech, Life Sciences, Microbiology. Interested and eligible candidates with MSc in...
CSIR-CFTRI Recruitment For Project Associate – Microbiology Apply Online
CSIR-CFTRI Recruitment For Project Associate - Microbiology Apply Online
CSIR-CFTRI Recruitment For Project Associate - Microbiology Apply Online. CSIR-CFTRI Job Openings. MSc Microbiology Jobs. Project...
SASTRA SRF Job For Bioinformatics, Biotech & Computational Biology
SASTRA University SRF Job For Bioinformatics, Computational Biology
SASTRA University MTech Biotech Project Assistant Recruitment. MTech Biotechnology, Bioinformatics and Computational Biology Vacancy at SASTRA University....
ICMR-NIN JRF Leading to PhD Opportunity For Biotech, Biochem & Microbiology
ICMR-NIN JRF Jobs - Biotech, Biochem & Microbiology Apply
ICMR-NIN JRF Jobs - Biotech, Biochem & Microbiology Apply. Project Junior Research Fellow leading to PhD...
ICAR-IVRI Biotech, Biochem & Microbiology YP Job Openings
IVRI Young Professional Jobs For Biotech, Biochem & Microbiology
IVRI Young Professional Jobs For Biotech, Biochem & Microbiology. ICAR-Indian Veterinary Research Institute Jobs. Young Professioanl-II...
Japanese Government [MEXT] Scholarship Program 2023 For Biotech & Biology
Japanese Government Scholarship 2023 For Biotech & Biology
The Government of Japan offers Government scholarships to Indian students for the academic year 2023 under...
ICAR-IARI Biotech, Biochem & Microbiology YP Job Openings
ICAR-IARI Jobs For Biotech, Biochem & Microbiology
ICAR-IARI Jobs For Biotech, Biochem & Microbiology. IARI Jobs 2022. ICAR-IARI job openings. Microbiology/Biotechnology/ Biochem young professional jobs....
R&D Manager Job at Unilever – Microbiology & Cell Biology Apply
R&D Manager Job at Unilever - Microbiology & Cell Biology Apply
R&D Manager Job at Unilever - Microbiology & Cell Biology Apply. PhD Microbiology &...
Sanofi Analyst QA Job For Biotech, Biochem & Microbiology – Apply Online
Sanofi Analyst QA Job For Biotech, Biochem & Microbiology - Apply Online
Sanofi Analyst QA Job For Biotech, Biochem & Microbiology - Apply Online. Interested...
Pfizer Associate Job Recruitment For Microbiology, Apply Online
Pfizer Associate Job Recruitment For Microbiology, Apply Online
Pfizer Associate Job Recruitment For Microbiology, Apply Online. Pfizer is hiring candidates for an Associate -Microbiology vacancy....
TUV SUD Food Microbiology Job Opening – Lead Auditor Vacancy
TUV SUD Food Microbiology Job Opening - Lead Auditor Vacancy
TUV SUD Food Microbiology Job Opening - Lead Auditor Vacancy. Interested and eligible applicants can...
CSIR-CFTRI Project Job Opening For Biotech, Biochem & Microbiology
CSIR-CFTRI Project Job Opening For Biotech, Biochem & Microbiology
CSIR-CFTRI Project Job Opening For Biotech, Biochem & Microbiology. CSIR-CFTRI Job Openings. MSc Biotech, Biochem and...
Govt QC Jobs For Food Tech & Microbiology at OMFED, Applications Invited
Govt QC Jobs For Food Tech & Microbiology at OMFED, Applications Invited
Govt QC Jobs For Food Tech & Microbiology at OMFED, Applications Invited. Food...
IASST Biotech & Microbiology JRF Recruitment, Apply Online
IASST JRF Vacancy For Biotech & Microbiology - Apply Online
IASST JRF Vacancy For Biotech & Microbiology - Apply Online. Institute of Advanced Study in...
























![Japanese Government [MEXT] Scholarship Program 2023 For Biotech & Biology Japanese Government Scholarship 2023](https://www.biotecnika.org/wp-content/uploads/2022/05/Japanese-Government-Scholarship-2023-150x150.jpg)